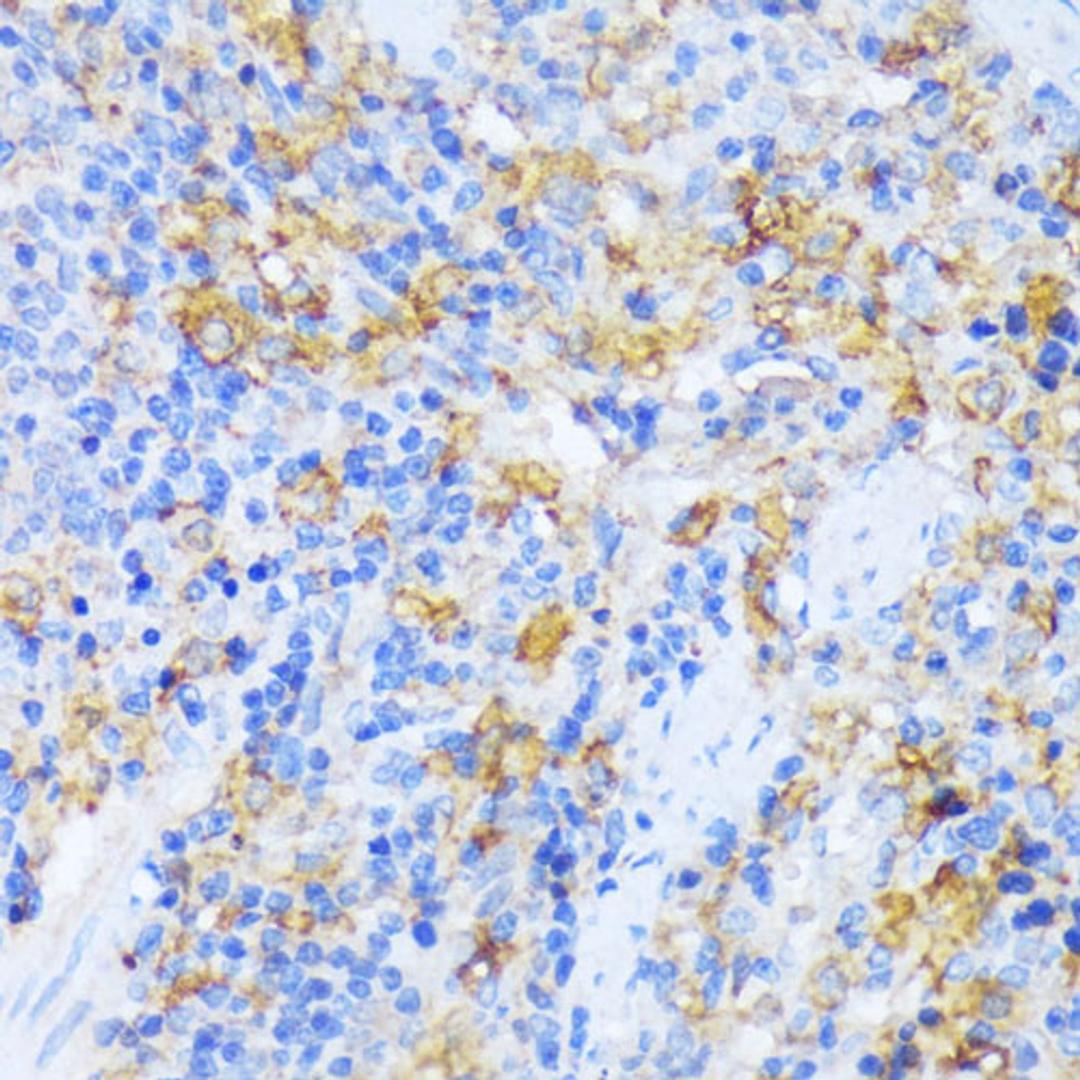
Immunohistochemistry - AARS antibody (A15017)

AARS Rabbit pAb
Product Details
- Cat. No.
- A15017
- Type
- Primary Antibody
- Clonality
- Polyclonal
- Host
- Rabbit

The supplier does not provide quotations for this antibody through SelectScience. You can search for similar antibodies in our Antibody Directory.
Description
The human alanyl-tRNA synthetase (AARS) belongs to a family of tRNA synthases, of the class II enzymes. Class II tRNA synthases evolved early in evolution and are highly conserved. This is reflected by the fact that 498 of the 968-residue polypeptide human AARS shares 41% identity witht the E.coli protein. tRNA synthases are the enzymes that interpret the RNA code and attach specific aminoacids to the tRNAs that contain the cognate trinucleotide anticodons. They consist of a catalytic domain which interacts with the amino acid acceptor-T psi C helix of the tRNA, and a second domain which interacts with the rest of the tRNA structure.
Biological Information
- Clonality: Polyclonal
- Host: Rabbit
- Reactivity: Human, Mouse, Rat